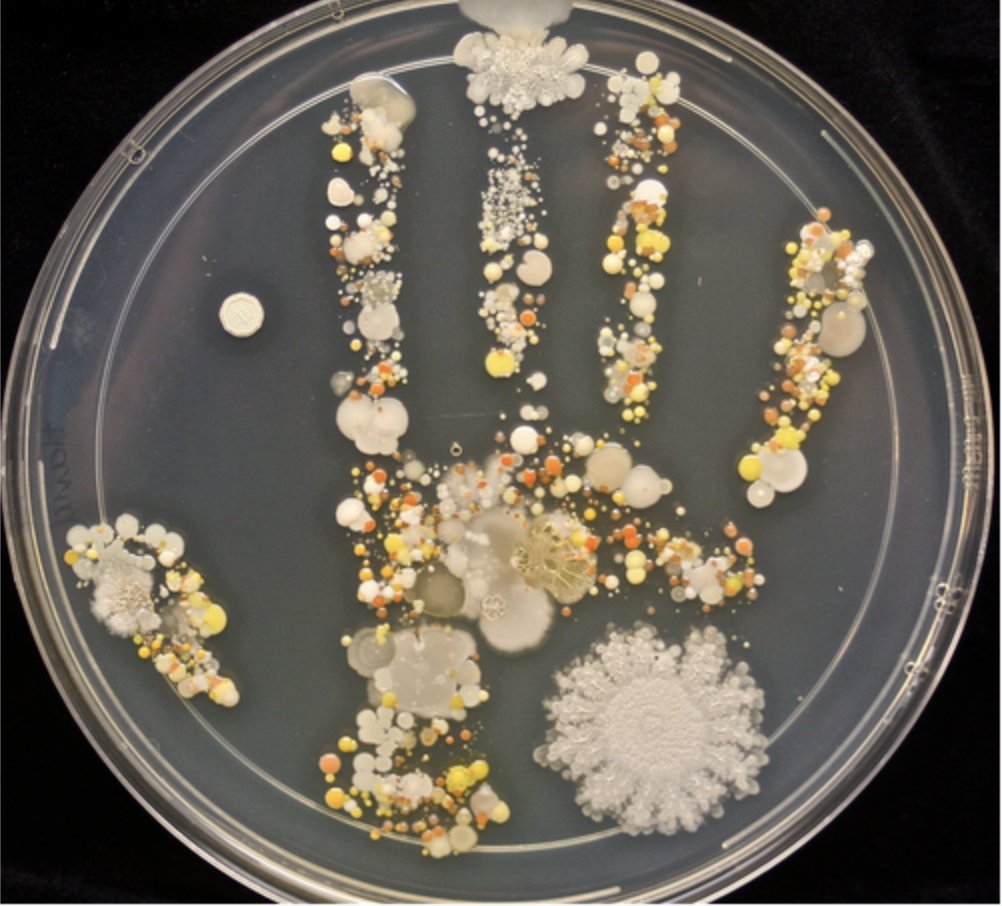

الأطباء لا يعقمون أيديهم فكيف بباقي الناس❗
دراسة عجيبة عن دقة البيانات وتفاعل الناس مع الحوافز:
سئل الأطباء عن معدل تعقيم أيديهم عند التنقل بين غرف المرضى وطُلب سرا من الممرضين مراقبتهم
النتيجة:
قال الأطباء أن المعدل هو 73%
لكن الممرضين قالو أن المعدل هو 9% فقط!
#مفاهيم_اقتصادية
دراسة عجيبة عن دقة البيانات وتفاعل الناس مع الحوافز:
سئل الأطباء عن معدل تعقيم أيديهم عند التنقل بين غرف المرضى وطُلب سرا من الممرضين مراقبتهم
النتيجة:
قال الأطباء أن المعدل هو 73%
لكن الممرضين قالو أن المعدل هو 9% فقط!
#مفاهيم_اقتصادية
🤔لم يكذب الأطباء، فما الذي حصل؟
عند إفصاح الناس عما فعلوا أو ما سيفعلون يقعون (بشكل واع/غير واع) في أخطاء التحيز الذاتي لذا:
"الكثير من أبحاث العلوم الاجتماعية تُثبت أن بيانات الإفصاح الذاتي تكاد تكون بلا قيمة" حسب #الاقتصادي ستيفن دوبنر
#مفاهيم_اقتصادية #تحليل_البيانات
🔴الحل:
عند إفصاح الناس عما فعلوا أو ما سيفعلون يقعون (بشكل واع/غير واع) في أخطاء التحيز الذاتي لذا:
"الكثير من أبحاث العلوم الاجتماعية تُثبت أن بيانات الإفصاح الذاتي تكاد تكون بلا قيمة" حسب #الاقتصادي ستيفن دوبنر
#مفاهيم_اقتصادية #تحليل_البيانات
🔴الحل:
شُكّلت لجنة متخصصة لتحفيز الأطباء على تعقيم أيديهم وحاولوا:
1⃣إرسال إيميلات تدعو الأطباء للحرص على تعقيم أيديهم، ولكن لم تجدي نفعا 👎
2⃣ توزيع كوبونات ستاربكس 10$ للأطباء الذين يُعقمون أيديهم، فأصبح الأطباء (بشكل غير واعي) يُعقمون أيديهم عندم رؤية موزعي الكوبونات فقط 👎
1⃣إرسال إيميلات تدعو الأطباء للحرص على تعقيم أيديهم، ولكن لم تجدي نفعا 👎
2⃣ توزيع كوبونات ستاربكس 10$ للأطباء الذين يُعقمون أيديهم، فأصبح الأطباء (بشكل غير واعي) يُعقمون أيديهم عندم رؤية موزعي الكوبونات فقط 👎
3⃣وضعت صورة حقيقية تبين للجراثيم المجهرية لأيدي طبيب لا يُعقم يديه بشكل كاف على جميع خلفيات أجهزة الكومبيوتر والشاشات في المستشفى👍
النتيجة:
معدل غسل الأطباء أيديهم ارتفع لـ 100%
اعتمدت مستشفيات عدة هذا الحل
يُعرف هذا الحل في #الاقتصاد_السلوكي بـ "Nudge" أو "التنبيه"
النتيجة:
معدل غسل الأطباء أيديهم ارتفع لـ 100%
اعتمدت مستشفيات عدة هذا الحل
يُعرف هذا الحل في #الاقتصاد_السلوكي بـ "Nudge" أو "التنبيه"
الفيديو المترجم:
youtu.be
المصدر (المحاضرة كاملة):
youtube.com
المزيد عن الـ "Nudge" أو "التنبيه/الوكزة" (#الاقتصاد_السلوكي):
youtu.be
المصدر (المحاضرة كاملة):
youtube.com
المزيد عن الـ "Nudge" أو "التنبيه/الوكزة" (#الاقتصاد_السلوكي):
جاري تحميل الاقتراحات...